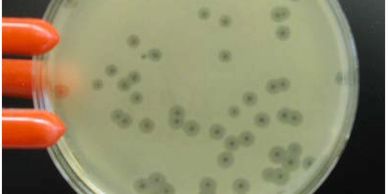

Phage UK's Network
The Citizen Phage Library
The Citizen Phage Library

Developing therapeutic phages to fight antimicrobial resistance with Citizen Science.
.
The Citizen Phage Library

.
.

.
.
.

.
.
.
.

.
.
.
.
.
This website uses cookies.
We use cookies to analyze website traffic and optimize your website experience. By accepting our use of cookies, your data will be aggregated with all other user data.